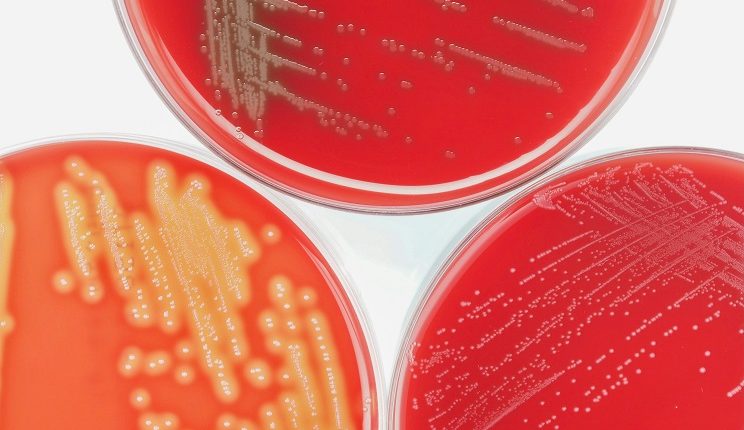

Semplifica la convalida dei metodi microbiologici e il controllo qualità in ambito ambientale e alimentare, gestendo incertezza, precisione e conformità secondo gli standard ISO (ISO 13843, ISO 29201, ISO 19036, ISO 11731, ISO 17025) in modo rapido, strutturato e digitalizzato, grazie alla piattaforma OQLAB.
La piattaforma OQLAB consente di gestire la convalida dei metodi di prova microbiologici, sia in campo ambientale, che alimentare.
Per le acque è possibile valutare la robustezza ed eseguire studi sulla dispersione dei dati da prove di ripetibilità secondo i requisiti della ISO 13843.

Per ricavare l’incertezza operativa il software fa riferimento alla norma ISO 29201, con la possibilità di scegliere tra l’approccio per regressione e quello per sottrazione in base alle necessità.
Ulteriori funzioni specifiche sono state sviluppate per la determinazione della legionella secondo le specifiche del metodo ISO 11731, mentre in campo alimentare il software elabora l’incertezza operativa secondo le indicazioni della ISO 19036.

Per la verifica della precisione, OQLAB offre un tool dedicato, con la possibilità di confrontare la ripetibilità intralaboratorio con i dati prestazionali dei metodi.
I tools sono completi di tutte le validazioni, con documenti conformi ai requisiti della ISO 17025.

Inoltre, è presente un tool dedicato al calcolo dei limiti di confidenza per le analisi su campioni di acque in conformità alla ISO 8199, ISO 29201 ed ISO 7218, con una serie di automatismi utili per valutare la conformità delle diluizioni e dei conteggi.

OQLAB offre una serie di applicativi dedicati all’assicurazione qualità, come prove in doppio, carte di controllo e gestione dei dati dei proficiency test, incluse le prove qualitative, dedicati al QA/QC dei metodi microbiologici.
Sono disponibili carte di controllo a variabili discrete per la verifica dell’accuratezza con limiti asimmetrici pensate per la verifica dei ceppi certificati, oppure con i test di Poisson.


È possibile verificare le prestazioni dei metodi qualitativi attraverso i test previsti dalla ISO 13843.

TUTTO QUESTO E MOLTO ALTRO SU WWW.OQLAB.COM
RICHIEDI DELLE CREDENZIALI DEMO



